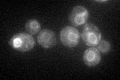
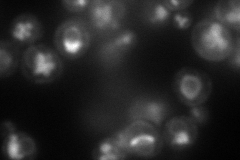

View description
ER membrane protein involved in a late step of glycosylphosphatidylinositol (GPI) anchor assembly; involved in the addition of phosphoethanolamine to the multiply mannosylated GPI intermediate; human PIG-Fp is a functional homolog
Localization:
Intensity:
Fold change:
Significance:
-
C’ GFP library in SD
ER58.73 -
N' NOP1pr-GFP in SD

ER73.4195 -
N' TEF2pr-mCherry in SD
ER,vacuole128.152 -
N' NATIVEpr-GFP in SD

ER29.7787 -
N' TEF2pr-VC and Cyto-VN in SD

ER33.6676 -
C’ GFP library in SD+DTT

ER64.221.09No -
C’ GFP library in SD+H2O2

ER51.690.88No -
C’ GFP library in Starvation Media

ERN/AN/AYes -
C’ GFP library on the background of Pup2-DaMP

ER -
C’ GFP library on the background of CCT mutant

ER59.69741.01634No
